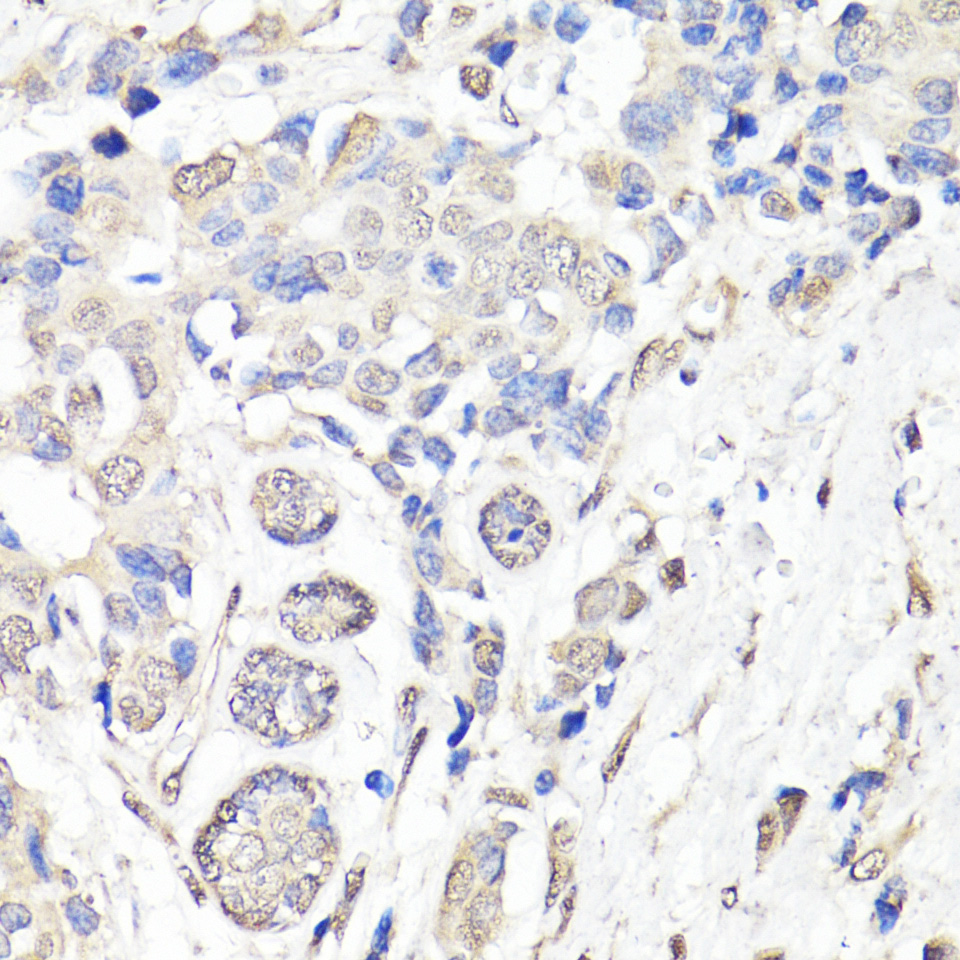
Immunohistochemistry - BAP1 Polyclonal Antibody

-
Product Name
BAP1 Polyclonal Antibody
- Documents
-
Description
Polyclonal antibody to BAP1
-
Tested applications
WB, IHC, IF
-
Species reactivity
Human, Mouse, Rat
-
Alternative names
BAP1 antibody; HUCEP-13 antibody; UCHL2 antibody; hucep-6 antibody; BRCA1 associated protein 1 antibody
-
Isotype
Rabbit IgG
-
Preparation
Antigen: Recombinant fusion protein containing a sequence corresponding to amino acids 460-729 of human BAP1 (NP_004647.1).
-
Clonality
Polyclonal
-
Formulation
PBS with 0.02% sodium azide, 50% glycerol, pH7.3.
-
Storage instructions
Store at -20℃. Avoid freeze / thaw cycles.
-
Applications
WB 1:500 - 1:2000
IHC 1:50 - 1:200
IF 1:50 - 1:200 -
Validations

Immunohistochemistry - BAP1 Polyclonal Antibody
Immunohistochemistry of paraffin-embedded human breast using BAP1 antibody at dilution of 1:150 (40x lens).
Immunohistochemistry - BAP1 Polyclonal Antibody
Immunohistochemistry of paraffin-embedded human breast cancer using BAP1 antibody at dilution of 1:150 (40x lens).
-
Background
Deubiquitinating enzyme that plays a key role in chromatin by mediating deubiquitination of histone H2A and HCFC1. Catalytic component of the PR-DUB complex, a complex that specifically mediates deubiquitination of histone H2A monoubiquitinated at 'Lys-119' (H2AK119ub1). Does not deubiquitinate monoubiquitinated histone H2B. Acts as a regulator of cell growth by mediating deubiquitination of HCFC1 N-terminal and C-terminal chains, with some specificity toward 'Lys-48'-linked polyubiquitin chains compared to 'Lys-63'-linked polyubiquitin chains. Deubiquitination of HCFC1 does not lead to increase stability of HCFC1. Interferes with the BRCA1 and BARD1 heterodimer activity by inhibiting their ability to mediate ubiquitination and autoubiquitination. It however does not mediate deubiquitination of BRCA1 and BARD1. Able to mediate autodeubiquitination via intramolecular interactions to couteract monoubiquitination at the nuclear localization signal (NLS), thereby protecting it from cytoplasmic sequestration. Acts as a tumor suppressor.
Related Products / Services
Please note: All products are "FOR RESEARCH USE ONLY AND ARE NOT INTENDED FOR DIAGNOSTIC OR THERAPEUTIC USE"
